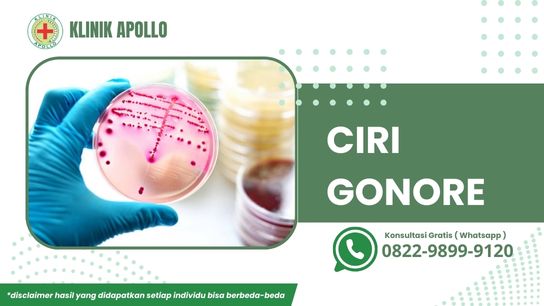

Gejala gonore yang sudah terinfeksi, masa inkubasi bakterinya sampai menimbulkan ciri yang klinis dan signifikan paling cepat 2-5 hari. Untuk gejala pada pria dan wanita sangatlah berbeda.
silakan klik untuk konsultasi dokter online
Umumnya perempuan yang mengalami gonore tidak mengalami gejala. Bahkan hanya sebagian wanita yang terinfeksi bisa menunjukan gejala. Tetapi ada baiknya untuk mengenali beragam ciri yang di timbulkan dari penyakit gonore.
Tentang Gonore
Gonore, juga dikenal sebagai kencing nanah, adalah infeksi menular seksual (IMS) yang disebabkan oleh bakteri Neisseria gonorrhoeae. Ini adalah salah satu infeksi menular seksual yang paling umum di seluruh dunia. Bakteri gonore dapat menginfeksi berbagai bagian tubuh, termasuk saluran kemih, organ reproduksi, tenggorokan, dan rektum.
Gonore menular terutama melalui kontak seksual, baik melalui hubungan seks vaginal, anal, atau oral. Bakteri dapat masuk ke dalam tubuh melalui selaput lendir di area genital, mulut, tenggorokan, atau rektum.
Ciri Penyakit Kencing Nanah atau Gonore
Penting untuk diingat bahwa tidak semua orang dengan gonore akan mengalami gejala, dan beberapa orang mungkin tidak menyadari bahwa mereka terinfeksi.
Tanpa pengobatan yang tepat, gonore dapat menyebabkan komplikasi serius seperti infertilitas, PID, dan penyebaran infeksi ke bagian tubuh lainnya.
Jika Anda memiliki kekhawatiran tentang kemungkinan infeksi gonore atau IMS lainnya, segera berkonsultasi dengan profesional kesehatan atau dokter spesialis penyakit menular.
Pemeriksaan dan pengobatan dini sangat penting untuk mencegah komplikasi lebih lanjut dan mencegah penyebaran infeksi. Berikut adalah beberapa ciri atau gejala umum gonore:

silakan klik untuk konsultasi dokter online
1. Pada Pria
l Uretritis
Pria yang terinfeksi gonore biasanya mengalami uretritis, yaitu peradangan pada uretra (saluran yang menghubungkan kantung kemih dengan ujung penis). Gejalanya meliputi nyeri atau sensasi terbakar saat buang air kecil dan keluarnya cairan yang berwarna putih, kuning, atau hijau dari penis.
l Pembengkakan Testis
Pada kasus yang lebih serius, gonore bisa menyebabkan peradangan pada testis yang dapat menyebabkan nyeri dan pembengkakan pada skrotum.
2. Pada Wanita
l Servisitis
Wanita yang terinfeksi gonore bisa mengalami servisitis, yaitu peradangan pada serviks (leher rahim). Gejalanya bisa termasuk nyeri perut bagian bawah, pendarahan di luar menstruasi, atau perubahan dalam keputihan.
l Radang Panggul (PID)
Jika tidak diobati, gonore pada wanita dapat naik ke rahim dan indung telur, menyebabkan PID yang serius. PID dapat menyebabkan nyeri panggul, demam, mual, dan bahkan gangguan kesuburan.
Pada Keduanya:
3. Gonore Rektal
Infeksi gonore pada rektum dapat menyebabkan gejala seperti nyeri saat buang air besar, keluar darah atau nanah dari rektum, atau sensasi gatal di daerah rektal.
4. Gonore Tenggorokan
Jika tenggorokan terinfeksi gonore (biasanya melalui seks oral), gejalanya bisa termasuk sakit tenggorokan dan nyeri saat menelan.
Konsultasi Gratis secara Online 24 Jam
Carilah referensi klinik untuk penyakit kelamin atau penyakit menular seksual terdekat. Dengan biaya terjangkau serta gratis layanan konsultasi secara online melalui Live Chat WA.
Klinik Spesialis Penyakit Kelamin ini memiliki dokter spesialis kulit kelamin serta staf medis yang berstandar internasional.
Pelayanan yang Kami berikan ramah dan memuaskan, sehingga pasien yang menjalani pengobatan pada klinik kami, serta alat medis yang canggih dan modern.
Bila memiliki penyakit menular seksual atau penyakit kelamin yang mengganggu, segeralah hubungi Klinik Utama Apollo pada nomor yang tertera diatas.
Disclaimer: Hasil dapat berbeda pada masing-masing individu.

